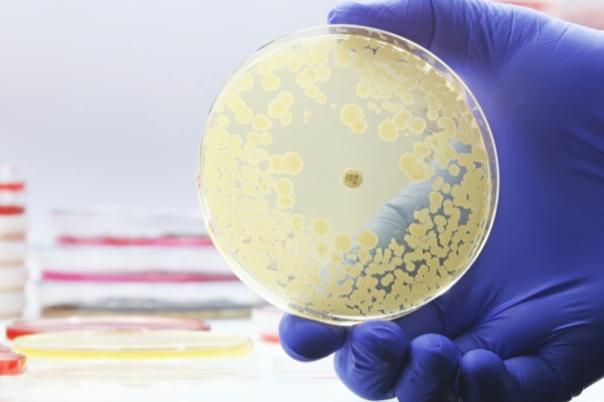

The integration will combine LigoLab’s all-in-one LIS and RCM platform with PathPresenter’s FDA-cleared clinical viewer, enabling labs to work within a single unified system.
This collaboration will let pathologists launch whole slide image viewers directly from their LIS environment, increasing efficiency, accuracy, and clinical speed. For lab managers focused on optimising workflows, this seamless connection facilitates improvements in turnaround time and operational performance.
Suren Avunjian, Chief Executive Officer of LigoLab, said: “By integrating the PathPresenter viewer with our LIS platform, we’ve created a unified environment where pathologists can move effortlessly from case data to high-resolution whole slide images.”
Alongside this, the solution offers an AI marketplace of plugins that will enable labs to tap into advanced algorithms and tools directly within their workflow. From a diagnostic and operational standpoint, this technology will give the labs a flexible platform that evolves jointly with the future of pathology.
While the adoption of digital pathology continues to grow, the need for integrated solutions remains urgent. This partnership between LigoLab and PathPresenter will deliver a future-ready system that fosters healthy competition between labs. Finally, the collaboration marks an important step in enhancing care quality.